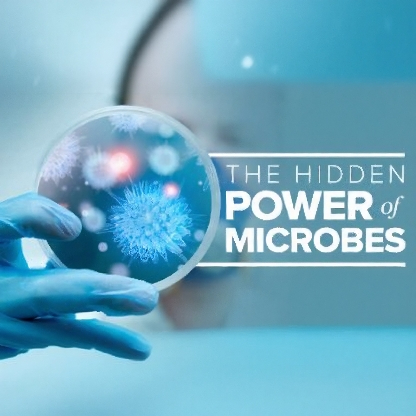

The Hidden Power of Microbes
Course Overview
An acclaimed science educator explores the secret lives of microbes in 24 fascinating lectures.
Course No. 80680
Your body hosts 38 trillion microbial cells and 380 trillion viruses – most essential to your survival. Dr. Melissa Booth, renowned science communicator, reveals how these invisible rulers shape:
- Human health: From digestion to mental health (can microbes control your mind?)
- Civilization: Fermentation secrets behind wine, cheese and chocolate
- Global systems: Ocean ecosystems, soil creation, and climate regulation
- Future solutions: Bioremediation, sustainable agriculture, and even space colonization
Through the story of fictional character Lina, you’ll discover why life on Earth (and beyond) depends on microbes.
Video Lectures
Module 1: Microbes & Human Health
- Welcome to the Microbial Jungle (27 min)
- How infant microbes shape lifelong health
- The Human Microbiome (28 min)
- Your body’s 39 trillion microbial inhabitants
- Skin, Gut, and Respiratory Microbes (26 min)
- Why we need microbes in our “germiest” areas
Module 2: Microbial Superpowers
- Fermentation: Wine, Cheese, Chocolate (27 min)
- Microbes as nature’s master chemists
- Survival of the Microbial Fittest (24 min)
- Chemical warfare and suicidal attacks in microbe battles
- Extreme Environment Survivors (27 min)
- Thriving in boiling vents, acid pools, and space
Module 3: Microbes in History
- How Microbes Were Discovered (30 min)
- From microscope revelations to germ theory
- Antibiotic Resistance Crisis (28 min)
- Are we entering a post-antibiotic era?
- Vaccine Breakthroughs (24 min)
- How we turned microbes against themselves
Module 4: Global Microbe Systems
- Marine Microbes (25 min)
- The invisible force producing Earth’s oxygen
- How Microbes Make Soil (23 min)
- Nature’s recycling system for nitrogen and carbon
- Extraterrestrial Microbes (27 min)
- Could Martian bacteria seed life elsewhere?
Module 5: Microbial Future
- Cutting-Edge Research (25 min)
- Electric bacteria and microbial cancer killers
- Solving Humanity’s Problems (30 min)
- Bioremediation, sustainable food, and climate solutions